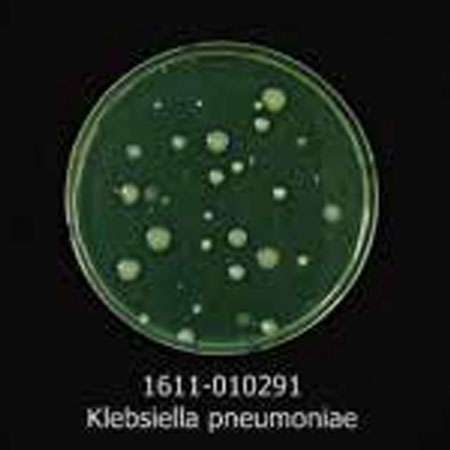

チューブナインクーレット
¥
1,430
税込

1983年創設の韓国ブランド。機能性を活かしたスポーツタオル生産を皮切りに、
アウトドアで便利なアクセサリーグッズを展開している。
ブランド名の「N・rit(エヌ・リット)」は、NATURAL SPIRITという言葉から生まれた。
ブランドシンボルには『フクロウ』をイメージアイコンとして採用。
フクロウは知恵の象徴でもあり身を守る術にも長け、人々に幸福をもたらす存在として愛され大切にされてきた。
自然との融合をテーマとして、スポーツやアウトドアライフを楽しむ人々の心に残る、
機能的でユニークな商品を展開している。
Dr.Bactyマークはアンチバクテリア加工による抗菌消臭機能に優れた商品である証です。
Dr.Barcty Protectionは、有機物と無機抗菌化合物の組み合わせで組成されています。
この加工は、細菌、真菌、藻類、カビ、酵母などに対して効果的です。バクテリアの繁殖を抑え消臭効果を発揮します。

(A) Contrast Bacteria
(Staphylococcus Aureus)
Control
Staphylococcus aureus

(A) Staphylococcus Aureus
1611-010291
Staphylococcus aureus

(A) Contrast Bacteria
(Klebsiella Pneumoniae)
Control
Klebsiella pneumoniae
(A) Klebsiella Pneumoniae
1611-010291
Klebsiella pneumoniae